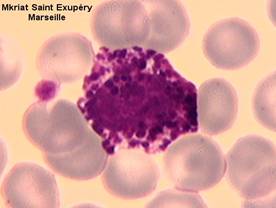

| CATEGORII DOCUMENTE |
| Alimentatie nutritie | Asistenta sociala | Cosmetica frumusete | Logopedie | Retete culinare | Sport |
SANGELE -MORFOLOGIA ELEMENTELOR FIGURATE
Din punct de vedere morfologic sangele apare ca o varietate de tesut conjunctiv, a carui substanta fundamentala lichida este plasma, iar celulele, elementele figurate ale sangelui.

Fig. 1 Plasma si elementele figurate
Practic la histologia sangelui studiem numai elementele figurate. Pentru aceasta executam frotiul sanguin si-l coloram in metoda panoptica May Grunwald Gimsa.
Elementele figurate din sange sunt:
-hematiile sau globulele rosii
-leucocitele sau globulele albe
-plachetele sanguine sau trombocitele.
 Pentru examinarea la microscop in vederea
diferentierii acestor celule si punerea unui diagnostic, vom insista
pe structura, dimensiunile si afinitatea lor tinctoriala.
Pentru examinarea la microscop in vederea
diferentierii acestor celule si punerea unui diagnostic, vom insista
pe structura, dimensiunile si afinitatea lor tinctoriala.
Hematiile (globulele rosii, eritrocitele)
Pe frotiul sanguin hematiile reprezinta majoritatea elemetelor celulare si sunt raspandite pe toata lama. Ele nu au nucleu, au forma de disc biconcav, cu diametrul de 7.1-7.3 microni. Miscand alternativ in sus si in jos viza micrometrica observam centrul hematiei mai subtire, mai palid colorat (la periferie hematia este mai groasa).
Aceste aspecte de mai sus
sunt datorate si faptului ca hematia contine in citoplasma
hemoglobina ,in cantitate mai  mare in zona periferica (unde
grosimea este mai mare) ; incarcarea cu hemoglobina este
uniforma si proportionala cu cantitatea de citoplasma.
In aspectul normal denumim aceasta ca izocromie, iar incarcarea
inegala cu hemoglobina (in starile patologice) anizocromie.
mare in zona periferica (unde
grosimea este mai mare) ; incarcarea cu hemoglobina este
uniforma si proportionala cu cantitatea de citoplasma.
In aspectul normal denumim aceasta ca izocromie, iar incarcarea
inegala cu hemoglobina (in starile patologice) anizocromie.
Dimensiunile hematiei sunt constante, (izocitoza), dar pot varia in plus sau in minus in diferite boli, (anizocitoza). Forma poate si ea varia, in stari patologice, aspect inelar, in racheta, (poikilocitoza).
Numarul hematiilor este constant (4-5 milioane hematii/ml. sange), iar numaratoarea hematiilor se face prin diferite metode. Variatiile in plus, peste limita superioara a numarului de hematii admis la omul normal le denumim poliglobulie ; aceasta poate fi fiziologica (la nou-nascut, la cei care traiesc la mare altitudine), sau patologica.
Scaderea numarului de hematii sub limita admisa ca normala- apare in stari de anemie, de obicei asociata cu scaderea incarcarii cu hemoglobina sau cu modificari de forma celulara.
Uneori hematiile pot prezenta resturi nucleare, de exemplu corpi Jolly- 1-3 granule bazofile sau resturi de membrana nucleara , Inelele Cabot, mai numeroase in stari patologice.
Leucocitele (globulele albe)
Aceste elemente figurate prezinta nucleu , deci sunt celule. Pe un frotiu sanguin colorat May Grunwald Gimsa, se pot observa aspecte de structura, numar, s.a
Dupa forma nucleului si prezenta (sau absenta ) in citoplasma a granulatiilor specifice, leucocitele se clasifica in :
-leucocite polimorfonucleare sau granulocite - neutrofile
- acidofile
- bazofile
-leucocite mononucleare sau agranulocite - limfocite
- monocite
Polimorfonuclearele neutrofile
Aceste leucocite apar pe frotiul colorat May Grunwald Gimsa ca celule sferice, de 9-15 microni, cu citoplasma acidofila care contine fine granulatii specifice, colorate in violet.Aceste granulatii au dimensiuni mici, sunt foarte dese si raspandite egal in toata citoplasma. Nucleul lor este format din mai multi lobi uniti intre ei prin filamente de cromatina. Numarul lobilor unui nucleu arata gradul de maturitate al granulocitului. Cu cat sunt mai multi lobi , 5-6, cu atat celula respectiva este mai batrana (formula Arneth).
In sangele recoltat de la femei, 80% din neutrofile prezinta un corpuscul cromatinian, sferic sau oval, atasat printr-un filament de unul din lobii nucleului. Acest corpuscul reprezinta cromatina sexuala si dupa aspect se numeste drumstick (betisor de toba).
 Numarul neutrofilelor dintr-o
suta de leucocite variaza intre 62-68 ; cand aceasta
proportie este mai mare, apare neutrofilia- ce caracterizeaza infectiile
acute, iar cand numarul lors cade, apare neutropenia.
Numarul neutrofilelor dintr-o
suta de leucocite variaza intre 62-68 ; cand aceasta
proportie este mai mare, apare neutrofilia- ce caracterizeaza infectiile
acute, iar cand numarul lors cade, apare neutropenia.
Polimorfonuclearele neutrofile intervin activ in apararea organismului, in procesele inflamatorii. Rolul lor este fie acela de a excreta fermenti proteolitici in focarul inflamator, ce vor actiona distrugand microbii sau tesuturile alterate, fie prin fagocitarea microorganismelor pe care le distrug apoi cu ajutorul fermentilor. Viata unui polimorfonuclear neutrofil este foarte scurta, se admite ca in sangele circulant ele nu depasesc 3-4 zile.
Fig.2 Polimorfonuclear neutrofil, col MGG, ob X40
Polimorfonuclearul acidofil (eozinofilul)
 Apare ca o celula sferica,
de12-17 microni. Nucleul este in general bilobat, cei doi lobi fiind
legati printr-o fina punte de cromatina (aspect de nucleu in
desaga). In citoplasma observam granulatii colorate in
rosu viu, egale intre ele, rotunde, uniform raspandite, mai mari
decat la neutrofile. Prin forma si culoarea lor, aceste granulatii
amintesc de Icrele de Manciuria. Granulatiile contin peroxidaze, diferite de mieloperoxidazele neutrofilelor
si hidrolaze acide.
Apare ca o celula sferica,
de12-17 microni. Nucleul este in general bilobat, cei doi lobi fiind
legati printr-o fina punte de cromatina (aspect de nucleu in
desaga). In citoplasma observam granulatii colorate in
rosu viu, egale intre ele, rotunde, uniform raspandite, mai mari
decat la neutrofile. Prin forma si culoarea lor, aceste granulatii
amintesc de Icrele de Manciuria. Granulatiile contin peroxidaze, diferite de mieloperoxidazele neutrofilelor
si hidrolaze acide.
Mobilitatea lui este scazuta si are o slaba capacitate de fagocitoza.
Proportia de eozinofile la suta de leucocite este de 1-3. Cresterea numarului lor poarta denumirea de eozinofilie, intalnita in stari alergice precum astmul, urticaria sau parazitoze, iar scaderea numarului lor, eozinopenie.
Fig.3 Eozinofil, ME. In microscopie electronica, granulatiile
sunt voluminoase, de 0.5-1.5 min diametru si contin o matrice granulara.
 Aceste celule actioneaza
sinergic cu celelalte celule in reactiile de hipersensibilitate de tip imediat
si intarziat. Ele au rol esential in
distrugerea parazitilor prin intermediul proteinelor (Eosinophil Cationic
Protein - ECP si Major Basic Protein - MBP) continute in cistalele
din granulatii . Membrana plasmatica are receptori pentru
IgE si pentru histamina. Numarul eozinofilelor poate fi
influentat hormonal. Granulocitul eozinofil are o
Aceste celule actioneaza
sinergic cu celelalte celule in reactiile de hipersensibilitate de tip imediat
si intarziat. Ele au rol esential in
distrugerea parazitilor prin intermediul proteinelor (Eosinophil Cationic
Protein - ECP si Major Basic Protein - MBP) continute in cistalele
din granulatii . Membrana plasmatica are receptori pentru
IgE si pentru histamina. Numarul eozinofilelor poate fi
influentat hormonal. Granulocitul eozinofil are o
viata mai lunga decat a neutrofilului, considerandu-se ca ajunge pana la 9-12 zile.
Fig. 4 Eozinofil, col MGG,ob. X40
![]()
Polimorfonucleatul bazofil.
Polimorfonucleatul bazofil.
Este o celula sferica de 10-14 microni. Nucleul bazofilului este ovalar, mai putin lobulat, aparand usor scobit, uneori ca o frunza de trifoi. Citoplasma desi usor acidofila, contine granulatii raspandite in citoplasma de culoare albastra, de forma si marime diferita, deseori suprapuse pe nucleu, mascandu-l.
Aceste granulatii bazofile sunt metacromatice. Bazofilul poate trece prin peretele capilar in tesuturi, transformandu-se in mastocit.
Fig. 5 Polimorfonucleatul bazofil., col. MGG, ob X40
 Proportia bazofilelor la suta de leucocite
este de 0.25-0.50. cresterea numarului lor, bazofilie, poate sa
ne indice o leucemie mieloida.
Proportia bazofilelor la suta de leucocite
este de 0.25-0.50. cresterea numarului lor, bazofilie, poate sa
ne indice o leucemie mieloida.
Mobilitatea lor este scazuta si nu fagociteaza. Pot trai in sange 12-15 zile.
Fig.6 Polimorfonucleatul bazofil, ME. In microscopia electronica granulatiile apar omogene formate din mici granule dense inconjurate de o membrana. Aceste granulatii bazofile contin histamina si heparina, (glicozaminiglicani sulfatati)
Limfocitul
Este o celula sferica, de 7-16 microni, cu nucleul mare ce ocupa aproape toata celula, sferic, intens colorat cu coloranti bazici, datorita faptului ca prezinta o cromatina bogata dispusa in grunji mari, conglomerati.
 Citoplasma este mult redusa, (apare
ca o banda ingusta dispusa in jurul nucleului), intens bazofila,
colorata in albastru. Obiectivul
cu imersie poate detecta inconstant in citoplasma, rare granulatii
mici, azurofile, nespecifice.
Citoplasma este mult redusa, (apare
ca o banda ingusta dispusa in jurul nucleului), intens bazofila,
colorata in albastru. Obiectivul
cu imersie poate detecta inconstant in citoplasma, rare granulatii
mici, azurofile, nespecifice.
Dupa dimensiunile lor se clasifica in :
-limfocite mici ( 7-8 microni)
-limfocite mijlocii ( 8-10 microni)
-limfocite mari (10-14 microni)
Fiecare dintre aceste limfocite prezinta caracteristici morfofunctionale (vezi cursul)
Fig.7 Limfocit, col. MGG, obX40
 Fig. 8 Limfocit, ME. In
microscopia electronica se observa ca nucleul prezinta
cromatina densa si nu prezinta nucleol. Citoplasma este saraca in
organite
Fig. 8 Limfocit, ME. In
microscopia electronica se observa ca nucleul prezinta
cromatina densa si nu prezinta nucleol. Citoplasma este saraca in
organite
Monocitul
Este leucocitul cel mai mare din sange, 16-20 de microni, are forma sferica sau ovalara, cu citoplasma abundenta, slab bazofila, putand prezenta granulatii nespecifice, azurofile. Nucleul este mare, deseori reniform, sarac in cromatina, avand aspect spongios. Cromatina este dispusa sub forma unor retele fine , slab cromatica, nu contine nucleol. Este socotit histiocit sanguin.
Numarul lor este de 6-10 la 100 leucocite. Cresterea numarului lor poarta denumirea de monocitoza, apare in boli infectioase : sifilis, etc.


 Fig. 9
Fig. 9
Fig. 10 Monocit, col MGG, ob.X40
Fig.11 Frotiu sanguin . Schema.
2. SANGELE -HEMATOPOIEZA

Fig. Maduva hematogena.

Fig. Hemomedula. Schema.



|
Politica de confidentialitate | Termeni si conditii de utilizare |

Vizualizari: 9519
Importanta: ![]()
Termeni si conditii de utilizare | Contact
© SCRIGROUP 2025 . All rights reserved